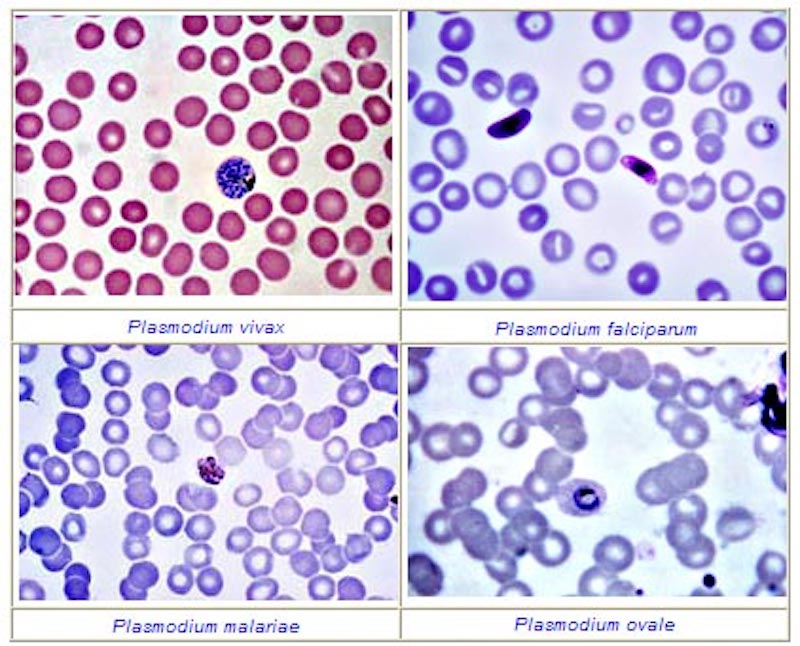

Nguyên nhân gây bệnh sốt rét chủ yếu là do muỗi truyền nhiễm, có liên quan chặt chẽ đến môi trường sống. Bệnh sốt rét xảy ra thường xuyên quanh năm, nhưng bệnh sẽ bùng phát vào mùa mưa ở khu vực đồi núi, nước lợ, vùng ven biển.
1Bệnh sốt rét do đâu?
Sốt rét là một bệnh truyền nhiễm nguy hiểm do một loại kí sinh trùng có tên Plasmodium gây nên, bệnh có thể truyền từ người này sang người khác thông qua vết cắn của muỗi Anophen.
Bệnh sốt rét được lây truyền qua đường máu và có 4 phương thức để lây truyền:
– Muỗi truyền nhiễm: Đây là phương thức chủ yếu của căn bệnh sốt rét.
– Truyền máu có nhiễm ký sinh trùng sốt rét.
– Mẹ truyền sang con do nhau thai bị tổn thương (hiếm).
– Tiêm chích: Sử dụng kim tiêm có dính máu của ký sinh trùng sốt rét, do tiêm chích ma tuý.
Ký sinh trùng sốt rét có tên là Plasmodium, là một chi của ký sinh trùng đơn bào thuộc lớp bào tử, để tồn tại và phát triển thì chúng bắt buộc phải ký sinh lên cơ thể của sinh vật. Hiện tại có trên 200 loài của chi này và đang được tiếp tục tìm hiểu thêm.
Ký sinh trùng sốt rét ký sinh ở cơ thể con người không phải chỉ có một loài duy nhất mà chúng có thể có nhiều loài, hình thái và khu vực sống khác nhau, sau đây là một số loại chính:
– P.falciparum: Ký sinh trùng được gặp nhiều ở vùng khí hậu nóng ẩm, mưa nhiều, nhiệt độ trung bình năm tương đối cao. Loại ký sinh trùng này thường gặp ở châu Á, châu Phi, châu Mỹ La Tinh và hiếm gặp ở châu Âu.
– P.vivax: Ký sinh trùng này gặp nhiều ở châu Âu còn châu Á và châu Phi chỉ gặp nhiều ở một số nơi.
– P.malariae: Xuất hiện ở châu Âu, châu Phi, ít ở châu Mỹ, châu Á thì rất hiếm gặp.
– P.ovale: Ký sinh trùng này khá là hiếm gặp trên thế giới, chỉ gặp ở trung tâm châu Phi.

2Giai đoạn ký sinh trùng sốt rét phát triển trong cơ thể người
Gian đoạn ký sinh trùng sốt rét ở gan:
Ký sinh trùng sốt rét sẽ tập trung ở tuyến nước bọt của muỗi, dưỡi dạng thoa trùng nếu muỗi mang mầm bệnh. Mỗi khi muỗi đốt, thoa trùng này sẽ theo tuyến nước bọt và đi xâm nhập vào cơ thể người cụ thể là vào hệ tuần hoàn. Sau tầm 30 phút xâm nhập vào hệ tuần hoàn, thoa trùng này sẽ di chuyển đến gan, xâm nhập vào tế bào gan và bắt đầu phát triển ở đây.
Trong gan, ký sinh trùng đầu tiên sẽ phát triển và lớn dần, mang bên trong hàng ngàn mảnh trùng hay còn gọi là thể phân cách. Khi thể phân cách này vỡ ra, chúng sẽ được phóng thích và đi vào trong máu. Tuỳ vào loại ký sinh trùng mà giai đoạn phát triển sẽ khác nhau. Plasmodium falciparum là 5 ½ – 7 ngày, Plasmodium vivax 6 – 8 ngày, Plasmodium ovale 9 ngày và Plasmodium malariae là 14 – 16 ngày.
Với Plasmodium vivax và Plasmodium ovale, ngoài sự phát triển tức thời của thoa trùng, nó còn có dạng thể ngủ trong gan. Thoa trùng sẽ xâm nhập vào tế bào gan nhưng không tiếp tục phát triển ngay để phân liệt mà nó sẽ nằm yên ở tế bào gan. Một vài tháng hoặc cả năm sau đó với một lí do chưa rõ, các thể ngủ sẽ phát triển cho ra phân liệt, sau đó phân liệt sẽ vỡ ra làm các mảnh trùng sẽ đi vào máu và làm tái phát bệnh sốt rét.
Plasmodium falciparum và Plasmodium malariae không có thể ngủ trong gan.
Giai đoạn ở hồng cầu
Các mảnh trùng được phóng thích ra từ gan sẽ xâm nhập tiếp vào hồng cầu để tiếp tục phát triển thành tư dưỡng. Từ thể tư dưỡng sẽ phát triển thành thể phân liệt chứa nhiều mảnh trùng. Số lượng mảnh trùng trong một phân liệt sẽ thay đổi tuỳ theo loài ký sinh trùng sốt két. Các phân liệt này sẽ vỡ ra để các mảnh trùng có thể xâm nhập vào các hồng cầu khác tiếp tục theo chu kì cho ra tư dưỡng rồi phân liệt. Sau nhiều chu kỳ, một số mảnh trùng sẽ phát triển thành thể giao bào đực và cái. Chúng sẽ không tiếp tục phát triển nữa mà chờ muỗi Anopheles hút vào dạ dày để phát triển tiếp.
Giai đoạn ký sinh trùng sốt rét phát triển hữu tính trong muỗi
Mỗi khi muỗi cái Anopheles đốt người có bệnh sốt rét, các thể ký sinh trùng sốt rét trong máu sẽ được hút vào dạ dày của muỗi, nhưng chỉ các thể giao bào là có thể tiếp tục phát triển thành thoa trùng. Thoa trùng này sẽ tập trung ở tuyến nước bọt của muỗi để tiếp tục truyền bệnh cho người khác.

Mong rằng với một vài chia sẻ trên đây sẽ giúp bạn hiểu rõ hơn về loại ký sinh trùng sốt rét, giúp bạn có những cách phòng tránh hiệu quả căn bệnh này.
Nguồn: st